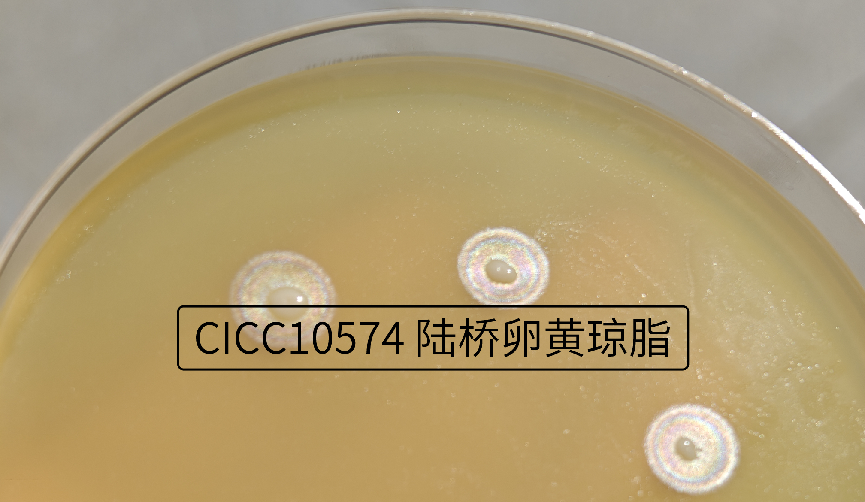

上篇“暴露”了唐菖蒲伯克霍爾德氏菌(椰毒假單胞酵米面亞種)的眾多“馬甲”�,本篇旨在說(shuō)明該菌耀眼奪目的內(nèi)在原因。它除了外界賦予的眾多“光環(huán)”���,還能自身產(chǎn)生光環(huán)���,下面小編詳細(xì)道來(lái)。

圖1??唐菖蒲伯克霍爾德氏菌“自帶光環(huán)”

圖2??唐菖蒲伯克霍爾德氏菌(椰毒假單胞酵米面亞種)檢驗(yàn)程序
按照《GB 4789.29-2020食品安全國(guó)家標(biāo)準(zhǔn) 唐菖蒲伯克霍爾德氏菌(椰毒假單胞酵米面亞種)檢驗(yàn)》標(biāo)準(zhǔn),使用GVC增菌后��,劃線mPDA和PCFA平板分離可疑菌??梢删涑鹾Y試驗(yàn)中�,最重要的就是接種卵黃瓊脂平板�,觀察菌落是否形成乳白色渾濁環(huán)�����,斜射光下菌落周圍培養(yǎng)基表面的虹彩現(xiàn)象。
我國(guó)專家(劉秀梅)在1979年就已經(jīng)注意到該菌在卵黃瓊脂上菌落周圍除乳白色渾濁環(huán)外,在陽(yáng)光斜射下表層有特殊虹彩環(huán)��,曾一度想命名為“虹彩黃桿菌”��。形成虹彩光環(huán)的主要原因是:
該菌產(chǎn)生卵磷脂酶和脂肪酶��;卵黃中的磷脂在卵磷脂酶的作用下,成為水溶性的磷酸酰膽堿和不溶性甘油三酯。磷脂酰膽堿被酶水解�����,產(chǎn)生甘油二酯,甘油二酯與卵黃中其他脂類生成白色沉淀物����,檢驗(yàn)者就可觀察到菌落周圍或底層有清晰的白色渾濁帶����。同時(shí)�����,脂肪酶將甘油三酯轉(zhuǎn)變?yōu)楦视投?����、單硬脂酸甘油酯和脂肪酸���。由于脂肪酸不擴(kuò)散�����,所以菌落周圍會(huì)形成圍繞著菌落的一層薄薄的油膜�����。當(dāng)光照射在膜上時(shí),膜的上下兩面都會(huì)反射光線���,兩列光波相遇就會(huì)發(fā)生相互干涉,此現(xiàn)象叫做“薄膜干涉”����。陽(yáng)光是紅�、橙��、黃����、綠��、青��、藍(lán)、紫七種單色光組成的復(fù)合光�����,當(dāng)陽(yáng)光斜射膜時(shí)�,由于膜的厚度不一,不同顏色的單色光在不同厚度的地方��,或增強(qiáng)或減弱或抵消�,最終呈現(xiàn)在油膜上的效果就是有不同顏色,這與機(jī)油滴在水面上���,反射彩虹光原理是一致的��。國(guó)外有些文獻(xiàn)對(duì)于脂肪酶反應(yīng)結(jié)果描述為“珍珠般”光澤�����,其實(shí)就是指“虹彩”現(xiàn)象�。

圖3? ?薄膜干涉示意圖

圖4? ?水面機(jī)油的彩虹現(xiàn)象
圖5??卵黃瓊脂上菌的虹彩現(xiàn)象
優(yōu)秀的人總是自帶光環(huán)���,但自帶光環(huán)的細(xì)菌�,很可能就是最兇狠���!該菌近幾年屢次引發(fā)食物中毒事件造成死亡。在檢驗(yàn)過(guò)程中����,檢驗(yàn)人員可以利用該菌的“光環(huán)”特征��,進(jìn)行甄別,但要注意���,務(wù)必在陽(yáng)光下觀察�����,才可看到反射的虹彩暈圈��。
?
參考資料:
1、J.J.Owens ?《The Egg Yolk Reaction Produced by Several Species of Bateria 》1974.
2��、Amy L.Leber, EDITOR IN CHIEF《Clinical Microbiology Procedures Handbook》4TH EDITION.
3、大 久保 忠 敬����,小 田隆 弘��,田 中恭 生,《コ ア グ ラ ーゼ陽(yáng) 性 ブ ドウ球 菌 の卵 黃 寒 天 培 地 に お け る卵 黃 反 応 に つ い て の一 考 察》